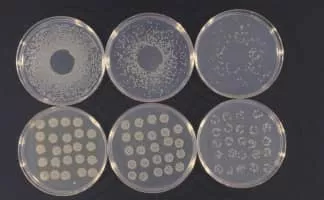
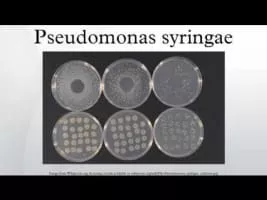

Pseudomonas Syringae
| Use attributes for filter ! | |
| Class | Gamma Proteobacteria |
|---|---|
| Scientific name | Pseudomonas syringae |
| Phylum | Proteobacteria |
| Higher classification | Pseudomonas |
| Order | Pseudomonadales |
| Rank | Species |
| Date of Reg. | |
| Date of Upd. | |
| ID | 2398955 |
About Pseudomonas Syringae
Pseudomonas syringae is a rod-shaped, Gram-negative bacterium with polar flagella. As a plant pathogen, it can infect a wide range of species, and exists as over 50 different pathovars, all of which are available to researchers from international culture collections such as the NCPPB, ICMP, and others.